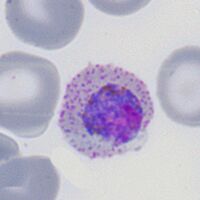

Plasmodium ovale: Morphology: Difference between revisions
From haematologyetc.co.uk
(Created page with "---- '''Navigation'''</br> <span style="font-size:80%">(click blue highlighted text to return to page)</span></br></br> <span style="font-size:90%">Malaria main index</span></br> <span style="font-size:90%">>Species identification: summary page</span></br> <span style="font-size:90%">>>This page: <u>''P.ovale'': morphology</u></span> ---- {| class="wikitable" style="border-style: solid; border-width: 5px; border-color: #023020; color:black" |colspa...") |
No edit summary |
||
| (8 intermediate revisions by the same user not shown) | |||
| Line 13: | Line 13: | ||
<gallery mode="nolines" widths=200px heights=200px> | <gallery mode="nolines" widths=200px heights=200px> | ||
File: | File:POETc.jpg|link={{filepath:POETc.jpg}} | ||
File: | File:POET main.jpg|link={{filepath:POET main.jpg}} | ||
</gallery> | </gallery> | ||
<br clear=all> | <br clear=all> | ||
This early growth stage has mainly large sized ring forms, but also begins to acquire characteristic features of the species. | |||
*Large and robust-appearing [[rings]], not usually multiply infected | |||
*Red cells may become enlarged and may be ovoid or have a [[fimbriated]] apearance | |||
* | *[[James' dots]] (indistinguishable from Schuffner’s dots) often appear | ||
* | *Pigment will not generally be present at the early trophozoite stage | ||
* | |||
<div style="width: 350px"> | <div style="width: 350px"> | ||
{| class="wikitable" style="border-left:solid 4px navy;border-right:solid 4px navy;border-top:solid 4px navy;border-bottom:solid 4px navy; font-size:90%; color:navy; align:center" | {| class="wikitable" style="border-left:solid 4px navy;border-right:solid 4px navy;border-top:solid 4px navy;border-bottom:solid 4px navy; font-size:90%; color:navy; align:center" | ||
| colspan="1"''|[[P. | | colspan="1"''|[[P.ovale early trophozoites gallery|Click for ''P.ovale'' early trophozoite gallery]]'' | ||
|} | |} | ||
</div> | </div> | ||
| Line 42: | Line 40: | ||
<gallery mode="nolines" widths=200px heights=200px> | <gallery mode="nolines" widths=200px heights=200px> | ||
File: | File:POLTc.jpg|link={{filepath:POLTc.jpg}} | ||
File: | File:POLT main.jpg|link={{filepath:POLT main.jpg}} | ||
</gallery> | </gallery> | ||
<br clear=all> | <br clear=all> | ||
| Line 49: | Line 47: | ||
During this growth stage parasites grows but generally retain a ring shape, this process is accompanied by further modification of the red cell with ovoid and fimbriated features more common; metabolism of haemoglobin causes malaria pigment to form. | |||
* | *Parasites become larger and thickened, but the ring form is generally retained | ||
* | *[[Red cell enlargement]] is seen and distortion causing ovoid and [[fimbriated]] forms | ||
* | *[[James’ dots]] will now be prominent in appropriately stained specimens | ||
*[[ | *[[Pigment]] will now be seen over the surface of the parasite | ||
<div style="width: 350px"> | <div style="width: 350px"> | ||
{| class="wikitable" style="border-left:solid 4px navy;border-right:solid 4px navy;border-top:solid 4px navy;border-bottom:solid 4px navy; font-size:90%; color:navy; align:center" | {| class="wikitable" style="border-left:solid 4px navy;border-right:solid 4px navy;border-top:solid 4px navy;border-bottom:solid 4px navy; font-size:90%; color:navy; align:center" | ||
| colspan="1"''|[[P. | | colspan="1"''|[[P.ovale late trophozoites gallery|Click for ''P.ovale'' late trophozoite gallery]]'' | ||
|} | |} | ||
</div> | </div> | ||
| Line 73: | Line 71: | ||
<gallery mode="nolines" widths=200px heights=200px> | <gallery mode="nolines" widths=200px heights=200px> | ||
File:PVSc.jpg|link={{filepath:PFSc.jpg}} | File:PVSc.jpg|link={{filepath:PFSc.jpg}} | ||
File: | File:POS main.jpg|link={{filepath:POS main.jpg}} | ||
</gallery> | </gallery> | ||
<br clear=all> | <br clear=all> | ||
| Line 79: | Line 77: | ||
The asexual stage of [[malaria parasite development]] - only some trophozoites form schizonts, but those that do undergo successive cycles of replication within the red cell to generate multiple [["merozoites"]] that then each invade a new red cell to continue and increase the infection. | The asexual stage of [[malaria parasite development]] - only some trophozoites form schizonts, but those that do undergo successive cycles of replication within the red cell to generate multiple [["merozoites"]] that then each invade a new red cell to continue and increase the infection. | ||
* | *A range of [[maturing schizonts]] will generally be present within moderately enlarged red cells | ||
* | *When mature schizonts may contain 16-24 separate [[merozoites]] | ||
*[[ | *[[James' dots]] can be detected in any residual cytoplasm of the erythrocyte | ||
*[[Malaria pigment|malaria pigment]] is visible in irregularly distributed clumps over the schizont surface | *[[Malaria pigment|malaria pigment]] is visible in irregularly distributed clumps over the schizont surface | ||
| Line 87: | Line 85: | ||
<div style="width: 350px"> | <div style="width: 350px"> | ||
{| class="wikitable" style="border-left:solid 4px navy;border-right:solid 4px navy;border-top:solid 4px navy;border-bottom:solid 4px navy; font-size:90%; color:navy; align:center" | {| class="wikitable" style="border-left:solid 4px navy;border-right:solid 4px navy;border-top:solid 4px navy;border-bottom:solid 4px navy; font-size:90%; color:navy; align:center" | ||
| colspan="1"''|[[P. | | colspan="1"''|[[P.ovale schizont gallery|Click for ''P.ovale'' schizont gallery]]'' | ||
|} | |} | ||
</div> | </div> | ||
| Line 102: | Line 100: | ||
<gallery mode="nolines" widths=200px heights=200px> | <gallery mode="nolines" widths=200px heights=200px> | ||
File: | File:POGc.jpg|link={{filepath:POGc.jpg}} | ||
File: | File:POG main.jpg|link={{filepath:POG main.jpg}} | ||
</gallery> | </gallery> | ||
<br clear=all> | <br clear=all> | ||
| Line 111: | Line 109: | ||
The sexual replication form (very distinctive). | The sexual replication form (very distinctive). | ||
* | *Red cells are very large and have ovoid or distorted forms | ||
* | *[[Macrogametocytes]] (female form) will often entirely fill the erythrocyte | ||
* | *[[Microgametocytes]] (male form) have a cytoplasmic rim with visible Schüffner's dots | ||
*[[Malaria pigment|malaria pigment]] is clumped evenly over the surface of the gametocyte | *[[Malaria pigment|malaria pigment]] is clumped evenly over the surface of the gametocyte | ||
| Line 119: | Line 117: | ||
<div style="width: 350px"> | <div style="width: 350px"> | ||
{| class="wikitable" style="border-left:solid 4px navy;border-right:solid 4px navy;border-top:solid 4px navy;border-bottom:solid 4px navy; font-size:90%; color:navy; align:center" | {| class="wikitable" style="border-left:solid 4px navy;border-right:solid 4px navy;border-top:solid 4px navy;border-bottom:solid 4px navy; font-size:90%; color:navy; align:center" | ||
| colspan="1"''|[[P. | | colspan="1"''|[[P.ovale gametocyte gallery|Click for ''P.ovale'' gametocyte gallery]]'' | ||
|} | |} | ||
</div> | </div> | ||
Latest revision as of 21:25, 13 December 2024
Navigation
(click blue highlighted text to return to page)
Malaria main index
>Species identification: summary page
>>This page: P.ovale: morphology
| The early trophozoite |
This early growth stage has mainly large sized ring forms, but also begins to acquire characteristic features of the species.
- Large and robust-appearing rings, not usually multiply infected
- Red cells may become enlarged and may be ovoid or have a fimbriated apearance
- James' dots (indistinguishable from Schuffner’s dots) often appear
- Pigment will not generally be present at the early trophozoite stage
| The late trophozoite |
During this growth stage parasites grows but generally retain a ring shape, this process is accompanied by further modification of the red cell with ovoid and fimbriated features more common; metabolism of haemoglobin causes malaria pigment to form.
- Parasites become larger and thickened, but the ring form is generally retained
- Red cell enlargement is seen and distortion causing ovoid and fimbriated forms
- James’ dots will now be prominent in appropriately stained specimens
- Pigment will now be seen over the surface of the parasite
| The schizont |
The asexual stage of malaria parasite development - only some trophozoites form schizonts, but those that do undergo successive cycles of replication within the red cell to generate multiple "merozoites" that then each invade a new red cell to continue and increase the infection.
- A range of maturing schizonts will generally be present within moderately enlarged red cells
- When mature schizonts may contain 16-24 separate merozoites
- James' dots can be detected in any residual cytoplasm of the erythrocyte
- malaria pigment is visible in irregularly distributed clumps over the schizont surface
The gametocyte
| The gametocyte |
The sexual replication form (very distinctive).
- Red cells are very large and have ovoid or distorted forms
- Macrogametocytes (female form) will often entirely fill the erythrocyte
- Microgametocytes (male form) have a cytoplasmic rim with visible Schüffner's dots
- malaria pigment is clumped evenly over the surface of the gametocyte